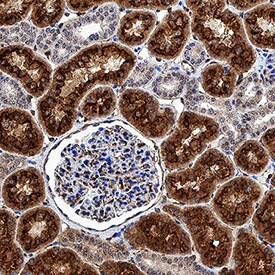
CUBN Antibody in Immunohistochemistry (Paraffin) (IHC (P))

Search
Invitrogen
CUBN Polyclonal Antibody
{{$productOrderCtrl.translations['antibody.pdp.commerceCard.promotion.promotions']}}
{{$productOrderCtrl.translations['antibody.pdp.commerceCard.promotion.viewpromo']}}
{{$productOrderCtrl.translations['antibody.pdp.commerceCard.promotion.promocode']}}: {{promo.promoCode}} {{promo.promoTitle}} {{promo.promoDescription}}. {{$productOrderCtrl.translations['antibody.pdp.commerceCard.promotion.learnmore']}}
图: 1 / 5
CUBN Antibody (PA5-47527) in IHC (P)





产品信息
PA5-47527
种属反应
宿主/亚型
分类
类型
抗原
偶联物
形式
浓度
规格
纯化类型
保存液
内含物
保存条件
运输条件
RRID
产品详细信息
In direct ELISAs and Western blots, less than 1% cross-reactivity with recombinant human (rh) Notch-2 and rhNotch-3 is observed.
Reconstitute at 0.2 mg/mL in sterile PBS.
靶标信息
Cubilin (CUBN) acts as a receptor for intrinsic factor-vitamin B12 complexes. The role of receptor is supported by the presence of 27 CUB domains. Cubulin is located within the epithelium of intestine and kidney. Mutations in CUBN may play a role in autosomal recessive megaloblastic anemia.
仅用于科研。不用于诊断过程。未经明确授权不得转售。
篇参考文献 (0)
生物信息学
蛋白别名: 460 kDa receptor; Cubilin; cubilin (intrinsic factor-cobalamin receptor); Cubulin; Glycoprotein 280; gp280; Intestinal intrinsic factor receptor; Intrinsic factor-cobalamin receptor; Intrinsic factor-vitamin B12 receptor; membrane receptor protein; unnamed protein product
基因别名: AA408369; AL022750; CUBN; D2Wsu88e; GP280; IFCR; IGS; IGS1; MGA1
UniProt ID: (Human) O60494, (Mouse) Q9JLB4, (Rat) O70244
Entrez Gene ID: (Human) 8029, (Mouse) 65969, (Rat) 80848